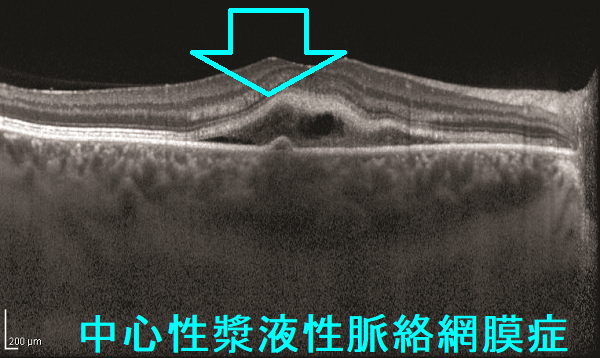
中心性漿液性脈絡網膜症 光干渉断層計(OCT) 中心性漿液性脈絡網膜症 光干渉断層計(OCT)

バセドウ病眼症(甲状腺眼症)と鑑別③網膜色素変性症,網膜裂孔,網膜静脈分枝閉塞症,中心性漿液性脈絡網膜症[橋本病 長崎甲状腺クリニック 大阪]
甲状腺:専門の検査/治療/知見① 橋本病 バセドウ病 甲状腺エコー 長崎甲状腺クリニック大阪
甲状腺専門の長崎甲状腺クリニック(大阪府大阪市東住吉区)院長が海外・国内論文に眼を通して得た知見、院長自身が大阪市立大学(現、大阪公立大学) 代謝内分泌内科で得た知識・経験・行った研究、日本甲状腺学会 学術集会で入手した知見です。
長崎甲状腺クリニック(大阪)以外の写真・図表はPubMed等で学術目的にて使用可能なもの、public health目的で官公庁・非営利団体等が公表したものを一部改変しています。引用元に感謝いたします。尚、本ページは長崎甲状腺クリニック(大阪)の経費で非営利的に運営されており、広告収入は一切得ておりません。
甲状腺・動脈硬化・内分泌代謝・糖尿病に御用の方は 甲状腺編 動脈硬化編 甲状腺以外のホルモンの病気(副甲状腺/副腎/下垂体/妊娠・不妊など) 糖尿病編 をクリックください。
長崎甲状腺クリニック(大阪)では、甲状腺眼症:バセドウ病眼症・橋本病眼症、眼の病気の診療を行っておりません。これらは眼科で行うものです。
バセドウ病眼症(甲状腺眼症)と鑑別③網膜色素変性症,網膜裂孔,網膜静脈分枝閉塞症,中心性漿液性脈絡網膜症(本ページ)
Summary
網膜色素変性症患者における甲状腺疾患の有病率は高い。バセドウ病/甲状腺機能亢進症では①凝固活性亢進・線溶系低下②血栓症を繰り返す抗リン脂質抗体症候群合併率も高いため、網膜静脈分枝閉塞症をおこす危険あり。中心性漿液性脈絡網膜症の原因は不明だが①ストレス②妊娠③副腎皮質ステロイド薬(の副作用);バセドウ病眼症(甲状腺眼症)・亜急性甲状腺炎・橋本病急性増悪・リーデル甲状腺炎(Riedel甲状腺炎)・橋本脳症の治療④甲状腺機能低下症/橋本病(慢性甲状腺炎)が関与。
Keywords
網膜色素変性症,甲状腺,バセドウ病,甲状腺機能亢進症,網膜静脈分枝閉塞症,中心性漿液性脈絡網膜症,副腎皮質ステロイド,甲状腺機能低下症,橋本病,網膜裂孔
網膜色素変性症(retinitis pigmentosa)は、遺伝子変異により網膜の視細胞と色素上皮細胞が変性する病気です。徐々に進行し、最初は暗い所で働く杆体細胞が障害され、夜盲と視野狭窄を来します。ビタミンA欠乏症と鑑別。進行すると視力低下、色覚異常、光視症、羞明が起こります。
視野検査では、中心と周辺の視野は残存し、ドーナツ状に視野が欠損する輪状暗点を認めます。 網膜電図ではa波、b波ともに消失し平坦化します。
網膜色素変性症患者における甲状腺疾患の有病率は高い[Am J Ophthalmol. 1996 Dec;122(6):903-5.]。
網膜色素変性症に
- 難聴、甲状腺疾患、白斑および円形脱毛症[Retina. 1982;2(2):84-8.]
- 橋本脳症[J Family Med Prim Care. 2020 Mar 26;9(3):1765-1767.]
を合併した報告があります
網膜裂孔(網膜の亀裂)の原因は、
- 加齢による硝子体変性
- 強度近視
- アトピー性皮膚炎
- 眼球の打撲
- 全身振動トレーニング運動[BMC Ophthalmol. 2020 Jan 29;20(1):37.]
(眼底写真;greeky medicsより改変)
網膜裂孔の症状は
- 飛蚊症
- 視力低下
- 光視症(白い光が見える)
- 昼盲(羞明のため)
網膜裂孔は細隙灯顕微鏡検査で前部硝子体に色素散布を認めます。
網膜裂孔は網膜剥離に進行するため光凝固療法の適応。
網膜中心動脈閉塞症(central retinal artery occlusion)は、目の脳梗塞と呼ばれ、根本的に脳梗塞・脳塞栓と同じ機序で発症します。頸動脈にできた血栓(artery to artery embolism)や心臓内血栓が網膜動脈まで飛んで閉塞を来します。網膜中心動脈閉塞症の危険因子は、
甲状腺眼症に対するトリアムシノロン注射後、トリアムシノロン粒子による網膜中心動脈閉塞症[Medicine (Baltimore). 2018 Apr;97(17):e0467.]
網膜静脈分枝閉塞症(branch retinal vein occlusion:BRVO)による網膜出血・黄斑浮腫では、片眼の視力低下が数週間で進行します。網膜静脈分枝閉塞症の診断は、
- 眼底検査;網膜出血・黄斑浮腫
- 蛍光眼底検査;網膜出血による蛍光ブロック
- 黄斑部の光干渉断層計(OCT);網膜出血・黄斑浮腫
網膜静脈分枝閉塞症の治療は、抗VEGF薬硝子体注射が第一選択。
バセドウ病/甲状腺機能亢進症では凝固活性が亢進し、血栓を分解するための線溶系が低下しているため、血栓を作り易いとされます。 (J Endocrinol Invest. 2002 Apr;25(4):345-50.)(J Clin Endocrinol Metab. 2007 Aug;92(8):3006-12.)
また、バセドウ病/甲状腺機能亢進症と血栓症を繰り返す抗リン脂質抗体症候群 の合併率も高いです(Eur J Endocrinol. 1997 Jan;136(1):1-7.)。(バセドウ病/甲状腺機能亢進症は血栓ができやすい?)。
バセドウ病/甲状腺機能亢進症は、網膜静脈分枝閉塞症の発症リスクを高める可能性があります。[Maedica (Bucur). 2024 Jun;19(2):380-387.]
中心性漿液性脈絡網膜症(central serous chorioretinopathy:CSC)は、30~50歳代の青壮年男性に多い。黄斑部(網膜の中心部)の浮腫による部分的な網膜剥離(漿液性網膜剥離)がおきて、視力低下や変視症(ものが歪んで見える)を来します。
中心性漿液性脈絡網膜症の原因は不明ですが、
- ストレス
- 妊娠
- 副腎皮質ステロイド薬(の副作用);バセドウ病眼症(甲状腺眼症)の治療、亜急性甲状腺炎の治療、橋本病急性増悪の治療、リーデル甲状腺炎(Riedel甲状腺炎)の治療、橋本脳症の治療
が関与するとされます。
中心性漿液性脈絡網膜症は、自然治癒することが多いものの、蛍光眼底造影でリークが確認されれば、レーザー治療の適応。
甲状腺機能低下症は中心性漿液性脈絡網膜症の発症に関連している可能性があります。[Semin Ophthalmol. 2019;34(7-8):533-540.][Eur J Ophthalmol. 2021 Nov;31(6):3223-3230.]
また、甲状腺機能低下症をおこす最大の原因である橋本病(慢性甲状腺炎)自体が、中心性漿液性脈絡網膜症の発症に関連している可能性もあります。[Med Hypotheses. 2018 Dec;121:180-182.]
うっ血乳頭(papilledema)とは、頭蓋内圧亢進による乳頭のうっ血です。頭蓋内圧亢進の原因として、
- 脳腫瘍
- 脳出血
- 脳膿瘍[Surg Infect (Larchmt). 2014 Jun;15(3):358-60.]
- 高血圧
- 甲状腺眼症:バセドウ病眼症 [Endocrinol Diabetes Metab Case Rep. 2022 Apr 1;2022:22-0240.][Horm Res Paediatr. 2022;95(1):88-92.]
- 特発性頭蓋内高血圧症
などがあります。
うっ血乳頭の症状は、
- 初期;霧視。視力は比較的保たれる
- 後期;中心部視野欠損(Mariotte盲点)が生じと視力低下
[Continuum (Minneap Minn). 2025 Apr 1;31(2):436-462.]
甲状腺関連の上記以外の検査・治療 長崎甲状腺クリニック(大阪)
長崎甲状腺クリニック(大阪)とは
長崎甲状腺クリニック(大阪)は日本甲状腺学会認定 甲状腺専門医[橋本病,バセドウ病,甲状腺超音波(エコー)検査など]による甲状腺専門クリニック。大阪府大阪市東住吉区にあります。平野区,住吉区,阿倍野区,住之江区,松原市,堺市,羽曳野市,八尾市,天王寺区,浪速区,東大阪市,生野区も近く。